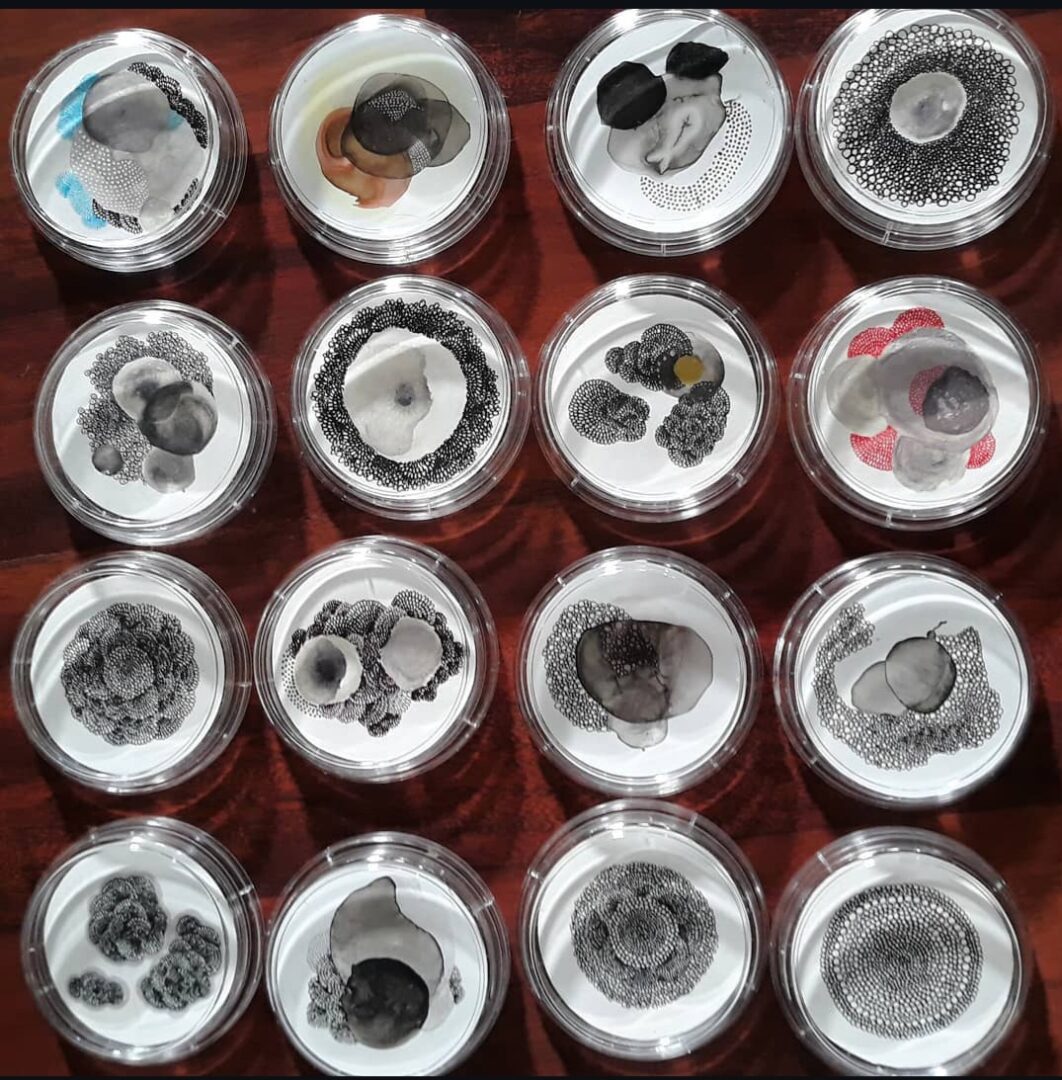

We’re excited to introduce you to the always interesting and insightful Margo Moore. We hope you’ll enjoy our conversation with Margo below.
Margo, so excited to have you with us today. So much we can chat about, but one of the questions we are most interested in is how you have managed to keep your creativity alive.
To keep creativity alive I simply do it. I don’t wait for inspiration, but make it a habit to make art whenever I can and I make space and time to do it. I carve moments throughout the day to squeeze in some work. For example, on my commute to work I listen to my audiobooks and draw at the same time. When I have the TV on, I rarely just sit and watch. Typically I have a couple of projects on the table in front of me and work on them as I watch TV. During my lunch breaks at work I take that hour to work on a page from my graphic novel and to catch up on art news through my favorite YouTube art channels. There is always something being produced while life flows daily, whether on the train, at work, in the doctor’s waiting room or before bed in my room. I simply create the time and space to do it. But it can’t be all create, create, work, work. I need to take breaks to recharge myself. To relax in the nature, take a train to the beach or go to breathe in forest air, or to simply go for a walk. Walking is where most ideas pop into my head. While I walk, my ideas somehow coalesce from all that I have read or seen or been experimenting with. Even going to a gallery to look at others’ artworks and from visiting a museum I gain a new vision and perspective on my own process.
Also, giving and contributing is an important part of creativity. I teach drawing and other art skill classes within my NYC community. This is an experience that gives me a refreshed gratitude.
Many times these experiences lead to further artistic collaborations with artists I meet in the community and those connections lead to further opportunities.

Let’s take a small detour – maybe you can share a bit about yourself before we dive back into some of the other questions we had for you?
I weave both art making and art teaching seamlessly into my daily life. By day, I work as a librarian, finding ways to infuse artistic opportunities into my role. Visual literacy is an increasingly essential form of communication, and I view my work as a librarian as both a privilege and a responsibility—one that allows me to share and cultivate that literacy with others. However, at my core, I am a visual artist, and my primary focus is on drawing and painting.
My most recent gallery exhibitions have centered on my circle paintings and drawings. These abstract pieces use circles as a visual representation of both the micro and macro worlds we inhabit. I use geometric shapes—especially circles—to explore the interconnectedness and universality of our experiences. The circle, with its perfect symmetry and infinite potential for variation, serves as a metaphor for the complexity of the universe. In my work, I layer circles of different sizes and colors to reflect the vastness and diversity of the outer world, while also drawing attention to the intricacies and interconnections of the inner world.
My aim is to create art that sparks contemplation and invites a deeper understanding of our place in the world. Through these pieces, I want to remind viewers of the beauty and complexity of the universe, while encouraging them to recognize the connections and possibilities within their own lives.
Alongside my visual work, I’ve been quietly developing a graphic novel that is semi-autobiographical. It tells the story of a young girl growing up in a Communist country in the 1980s, offering her often humorous perspectives on the world around her. The narrative is told through the lens of a child, tackling serious issues with innocence and wonder. This project has been years in the making, and as I near its completion, I’m struck by just how consuming the process of writing and illustrating a book can be. I expect to finish this chapter soon, but the next one is already on my mind: the story of moving to America.
Looking back, what do you think were the three qualities, skills, or areas of knowledge that were most impactful in your journey? What advice do you have for folks who are early in their journey in terms of how they can best develop or improve on these?
The most important part of keeping creativity alive is just doing it. It’s not waiting for inspiration to come or making one piece a year and sitting back. It’s a process that opens itself up while we make the work. Nothing will come out of laziness and we shouldn’t expect it to. So I would say being industrious is a highly needed quality while we develop our artistic skills. Being well-read in the area of art history and in current artistic trends and events is most helpful as well. We need to be well versed in the art speak, but also knowledgeable in what is being challenged and championed in the arts at the current moment. And the ability to be versed in current events from other perspectives will bring us closer to a wider discourse. The artist is not an island as much as some may romanticize this to be. An artist is a magic maker with exceptional skills that floats through social circles.

One of our goals is to help like-minded folks with similar goals connect and so before we go we want to ask if you are looking to partner or collab with others – and if so, what would make the ideal collaborator or partner?
As mentioned above, part of my artistic growth is putting my work and myself out there. Collaborating with other creatives is what drives our community further. Right now I am looking to be a part of like-minded individuals or groups who aren’t afraid to venture into this unknown and to grow. I am planning a group show for librarian artists who make portraits and another for people with abilities who create. I would love to work on a larger collaborative project with a them or open that would lift creatives in the New York City area and beyond. Since many of us exist online, the possibilities grow.

Contact Info:
- Website: https://margoartstudio.carrd.co/
- Instagram: https://www.instagram.com/margo_art_studio
Image Credits
Margo Moore
